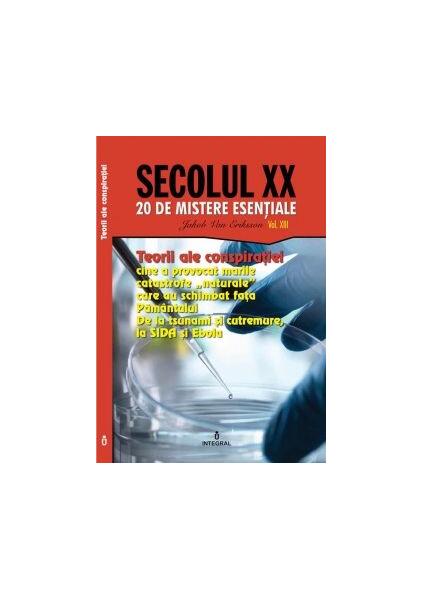

Jakob van Eriksson
Teorii ale conspirației. Cine a provocat marile catastrofe „naturale” care au schimbat fața Pământului (Vol. 13) - Jakob van Eriksson - Integral
Teorii ale conspirației. Cine a provocat marile catastrofe „naturale” care au schimbat fața Pământului (Vol. 13) - Jakob van Eriksson - Integral
Preț normal
15,85 lei
Preț normal
Pret redus
15,85 lei
Pret pe bucată
pe
Este cert că astăzi există o mulțime de „războaie secrete”, care nu se duc cu mijloacele convenționale precum tancurile, mitralierele sau avioanele de luptă, ci cu metode total diferite, care presupun...
Produse recomandate
-
The Confession of an atheist priest - Paperback brosat - Ion Aion - Curtea Veche
Marcă:Ion AionPreț normal 68,71 leiPreț normalPret pe bucată pe -
Promoție
Atinge-ți obiectivele - Curtea Veche
Marcă:trumiaPreț normal 47,21 leiPreț normalPret pe bucată pe49,69 leiPret redus 47,21 leiPromoție -
Promoție
Despre motivație - Curtea Veche
Marcă:trumiaPreț normal 50,22 leiPreț normalPret pe bucată pe52,86 leiPret redus 50,22 leiPromoție -
Regulile atașamentului - Curtea Veche
Marcă:trumiaPreț normal 73,31 leiPreț normalPret pe bucată pe77,17 leiPret redus 73,31 leiPromoție -
Promoție
Menopauza - Curtea Veche
Marcă:trumiaPreț normal 56,24 leiPreț normalPret pe bucată pe59,20 leiPret redus 56,24 leiPromoție -
100 de legi eterne ale succesului în business - Brian Tracy - Curtea Veche
Marcă:Brian TracyPreț normal 50,74 leiPreț normalPret pe bucată pe -
21 de secrete ale antreprenorilor de succes - Brian Tracy - Curtea Veche
Marcă:Brian TracyPreț normal 30,66 leiPreț normalPret pe bucată pe -
69 Q&A - Radu F. Constantinescu - Curtea Veche
Marcă:Radu F. ConstantinescuPreț normal 60,26 leiPreț normalPret pe bucată pe63,43 leiPret redus 60,26 leiPromoție
- Alegerea unei selecții va reîncărca pagina.
- Deschide într-o nouă fereastră.